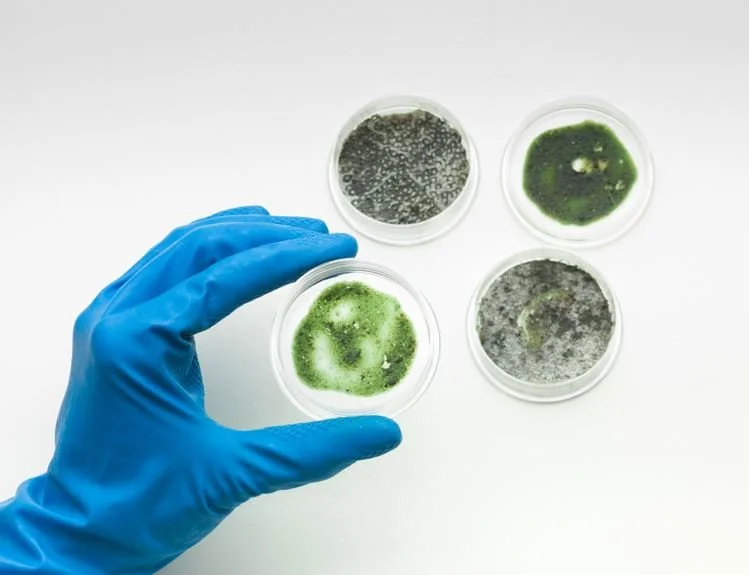

Leveraging Expert Legal Witnesses in Mold Cases
Expert Witnesses Provide Legal Validation for Mold and Mycotoxin Cases
In the intricate realm of legal proceedings, the role of expert witnesses is paramount. These individuals bring a wealth of knowledge and experience to the courtroom, helping to explain complex subjects and validate legal claims. Medical Consultation Services, PA (MSCPA), and Dr. Dennis Hooper stand out as exemplars in the field, their expertise serving as a linchpin for numerous legal cases. The services of an experienced expert witness can underscore the reliability and credibility of your testimony.
Basis for Expert Opinion
One of the foundational aspects of an expert witness's credibility lies in the basis for their opinion. In the case of MSCPA and Dr. Dennis Hooper, their opinions are firmly rooted in a combination of academic qualifications, professional experience, and a comprehensive understanding of their respective fields. MSCPA, as a collective entity, comprises a team of seasoned mole and mycotoxin professionals, each with a wealth of practical experience and a commitment to evidence-based practice. Dr. Dennis Hooper, with his specialized knowledge in a specific medical domain, provides a solid foundation for his expert opinions, drawing from years of clinical practice and research.
Distinguishing Between Junk Science and Hard Science
The nature of the expertise offered by an expert witness is a critical factor in evaluating the strength of their testimony. The distinction between "junk science" and "hard science" is pivotal in determining the reliability of the expert's conclusions. In the case of MSCPA and Dr. Hooper, their testimonies are firmly rooted in established scientific principles and methodologies. The medical insights provided by MSCPA are based on rigorous scientific research and accepted medical practices, ensuring that their testimony falls squarely within the realm of "hard science." Similarly, Dr. Hooper's expertise is deeply entrenched in the rigorous methodologies of his medical discipline, reinforcing the credibility of his opinions.
Subjective Interpretation in Expert Testimony
A potential challenge in expert testimony lies in the degree of subjectivity inherent in certain fields. However, both MSCPA and Dr. Hooper are adept at navigating this challenge. They approach their testimonies with a commitment to objectivity, relying on concrete evidence and established standards within their fields. While some degree of interpretation may be necessary in certain medical cases, the experts ensure that their interpretations are firmly grounded in the principles of their respective disciplines.
Peer Review and Publication Record
An expert's technique or theory gains substantial validation through the peer-review process and their publication record. In the case of MSCPA, the collective expertise is often subjected to rigorous peer review within the medical community. This ensures that their methodologies meet the highest standards of scrutiny, enhancing the reliability of their testimony. Dr. Hooper, with a robust publication record, not only demonstrates his commitment to advancing medical knowledge but also provides a tangible record of his contributions to the field.
Acceptance in the Scientific Community
The acceptance of a technique or theory within the scientific community is a litmus test for its reliability. In both MSCPA's collective expertise and Dr. Hooper's individual contributions, the techniques and theories they offer have garnered recognition within their respective fields. This acceptance is not only a testament to the validity of their approaches but also enhances the weight of their testimonies in legal settings.
Next Steps for Securing an Expert Mold Witness
As legal cases become increasingly complex, the reliance on seasoned experts like MSCPA and Dr. Hooper becomes not just beneficial but essential in navigating the intricate landscape of expert testimony. When it comes to mold and mycotoxins, MSCPA is a trusted partner that ensures the strongest possible foundation for legal proceedings. If you have questions or wish to explore our services further, please do not hesitate to schedule a brief consultation to discuss your case.